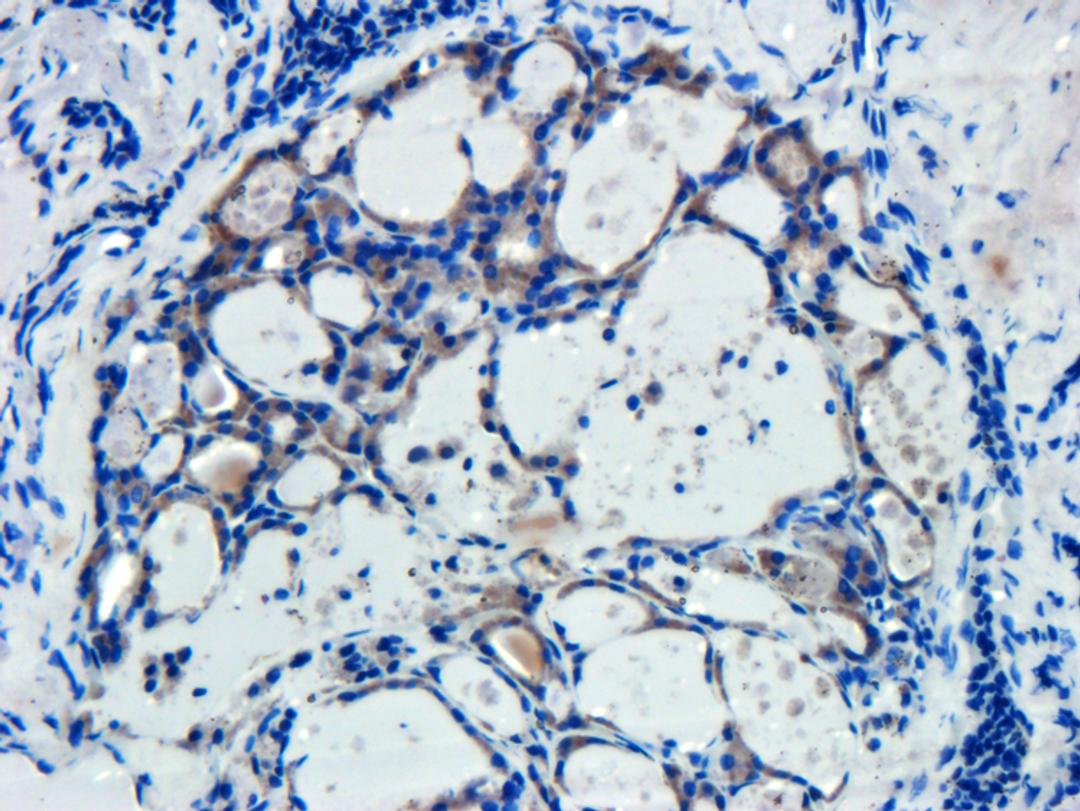
Immunohistochemical staining of human breast cancer tissue using beta actin antibody (dilution of primary antibody - 1:200)

Product & ReviewsAntibodies
beta Actin antibody
Product Details
- Cat. No.
- orb181785
- Type
- Primary Antibody
- Clonality
- Polyclonal
- Host
- Rabbit

The supplier does not provide quotations for this antibody through SelectScience. You can search for similar antibodies in our Antibody Directory.
Description
Rabbit polyclonal antibody to beta actin; which is also known as PS1TP5BP1 and BRWS1. Actin is frequently found in the cytoplasmic mRNP granules containing untranslated mRNAs and is expressed in the whole blood and adrenal gland. It is overexpressed in the neutrophil and T lymphocytes. Actins are highly conserved proteins that are involved in various types of cell motility and are ubiquitously expressed in all eukaryotic cells and are major constituent of microfilaments.
Biological Information
- Clonality: Polyclonal
- Host: Rabbit
- Reactivity: Human, Mouse
- Clone: NULL
- Conjugate: Unconjugated
- Isotype: IgG
- Gene: NULL
Handling
- Quantity: 100 ?g; 200 ?g
- Storage: NULL
- Buffer: 10 mM PBS; 0.02% sodium azide
Applications
- ELISA (ELISA)
- Immunofluorescence (IF)
- Immunohistochemistry (Paraffin-Embedded Sections) (IHC (P))
- Western Blotting (WB)